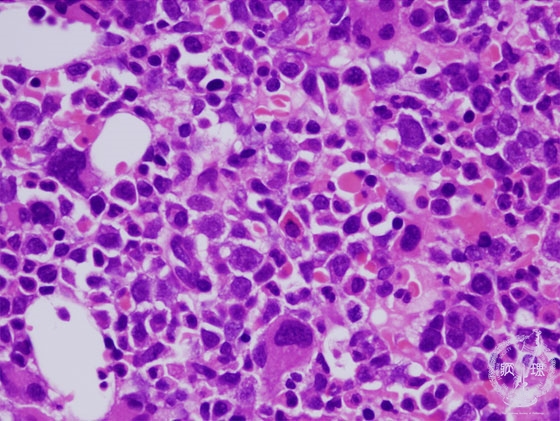

- 1.Bone marrow / Hematopoietic system
- ★(4) Myelodysplastic syndrome (MDS)
Microscopic image (H&E high power view): The marrow is hypercellular by excessive blasts with disordered differentiation in varying degrees. Myeloid blasts make up less than 20%. While marrow cells in three lineages increase markedly, megakaryocytes are also dysplastic (arrows).
Click the image to see the enlarged image.